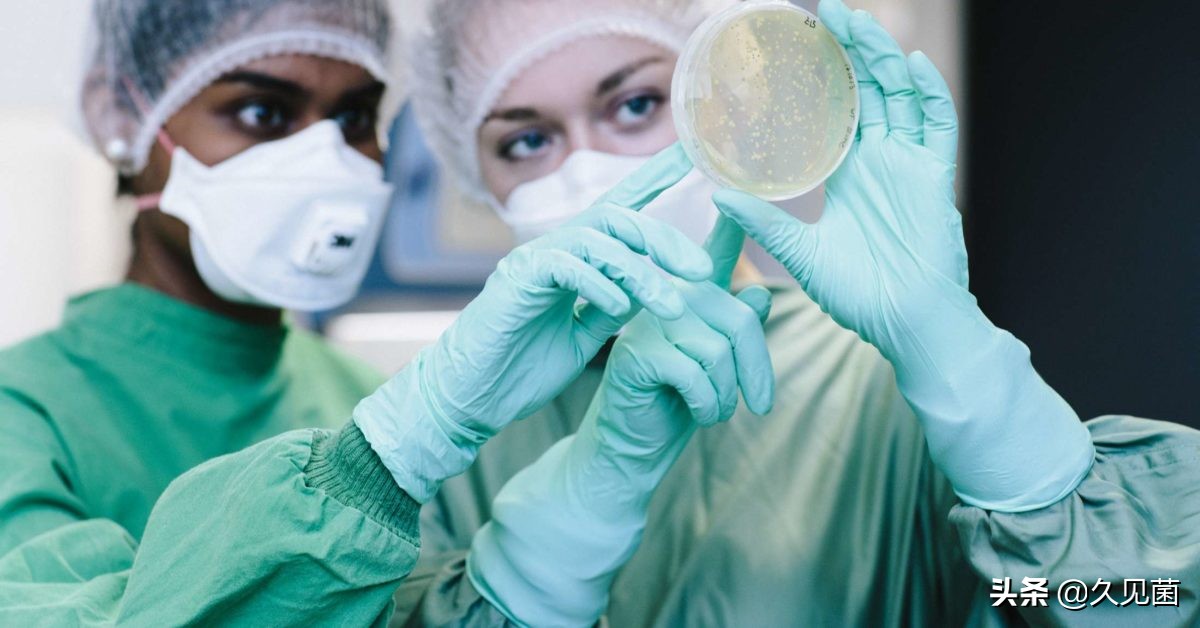
寄生虫灭绝了对生态有影响吗,寄生虫离开人体多久会死亡

我们总是谈寄生虫色变,一提到寄生虫就会让我们产生厌恶的情绪,在各种影视作品中,寄生虫也被刻画成十分恐怖的形象,韩国有部电影叫做铁线虫入侵,就是讲的寄生虫入侵韩国的故事。确实有很多疾病是由于寄生虫寄生导致的,但是你知道吗?寄生虫也有保护健康的功效,盲目消灭寄生虫只会危害到我们自身。

图为电影《铁线虫入侵》
为什么要保护寄生虫
在国内有很多常见的寄生虫疾病,如蛔虫病、鞭虫病、弓形虫病、疟疾病等等由寄生虫引发的疾病。但是我们也要意识到所有已知的寄生虫中只有4%会感染到人类,而且大部分的寄生虫还没有被人类发现或命名,它们广泛存在于自然界中,对整个生态系统起到我们还没有完全了解的调节作用。
1、调节生态系统中物种的数量。
拿我们熟悉的铁线虫为例,铁线虫会寄生在蟋蟀的身上,它寄生蟋蟀的方式就是在蟋蟀取食其它昆虫尸体的时候进入蟋蟀的体内,在蟋蟀体内长大,蟋蟀一般是不会靠近水源的,而铁线虫需要在水中生存,所以在铁线虫生长成熟之后,它就会改变蟋蟀的大脑,使其向水中移动,在这一过程中,蟋蟀很有可能就会被淹死。

图为铁线虫入侵蟋蟀
蛇形虫草属真菌,有点像我们中国的名贵药材:冬虫夏草。蛇形虫草属真菌的孢子落在蚂蚁的身上,就会钻入蚂蚁的外骨骼,进入他们的大脑,驱使它们离开自己的巢穴,爬到附近的树上,而这种真菌就会刺穿蚂蚁的外壳让孢子继续传播,感染更多的蚂蚁。

图为蛇形虫草属真菌寄生蚂蚁
尖头蠕虫会入侵到一些端足类生物的体内,它们的最终目的是为了进入海鸟的体内,在鸟类的体内生存下来,因此它们会让被寄生的宿主大脑发生变异,将其驱赶到光明开放的地区,使其更容易捕食。
除此之外,还有许许多多的例子都在证明,寄生虫正在调节整个生态系统的种群数量。

图为尖头蠕虫寄生端足类
2、寄生虫正在保护生物体的健康
鲨鱼的寄生虫正在保护鲨鱼的身体健康,伊朗德黑兰大学的教授做过这样一项实验,调查鲨鱼肚子中寄生虫的情况,伊朗德黑兰大学团队解剖了16只生活在波斯湾的白颊鲨鱼,取出它们肚子中的绦虫,化验绦虫体内和鲨鱼体内重金属含量,科学家惊奇地发现绦虫体内有毒物质镉的含量比鲨鱼体内镉的含量高出了278倍到455倍。
我们由此可以得出结论,虽然说绦虫寄生在鲨鱼体内吃掉了鲨鱼体内的一些营养物质,但是绦虫也起到了为鲨鱼过滤有毒物质的作用,保护了鲨鱼的健康。

图为白颊鲨鱼
寄生虫不光会保护在大自然的野生动物,对于人类也起到了防治疾病的作用。
在生物数百万年的进化史中,寄生虫一直和宿主的免疫系统做着斗争,而它为了防止免疫系统将自身排出体内,它们会分泌一定的化合物质,麻痹宿主的免疫系统,从而逃过免疫系统的追杀,让自己能在宿主的身体里安然地活下去。这一串神奇的操作已经存在于生物体上百万年的时间了,在自然的进化中,生物体已经习惯了这种方式,如果说突然将所有的寄生虫全部排除的话,免疫系统就会少了敌人,势必会引发一些过激反应,也就是我们常说的过敏。

图为人体过敏的过程
我们以肠道寄生虫为例,在美国这种发达国家,人们通过先进的医疗技术已经消灭了大多数肠道寄生虫,但是这也让人体患上了自身的免疫系统疾病,当美国人清除掉了肠道的寄生虫的时候,人体自身的免疫系统就开始发生一些过激反应,患有克罗恩氏病的人甚至会故意感染肠道蠕虫,尝试恢复肠道的生态平衡,但是这一治疗方法的效果还有待进一步证明。

图为肠道的寄生虫
寄生虫种群的数量正在减少
随着全球气候变暖和人类的生产活动,生物的种群数量正在急剧减少,据统计,全世界每天有75个物种灭绝,伴随着物种灭绝,它们身上寄生的寄生虫也在濒临灭绝,在未来50年,10%的寄生虫即将濒临灭绝,很多寄生虫都要寄生在特定的生物体内,如果这种物种灭绝,很有可能导致它们失去了专有寄生的环境,很多的寄生虫长时间寄生在特有的环境之中,都不太具备适应环境的能力。

图为寄生虫
生活在喜马拉雅山山麓草地上的侏儒猪,它们的数量正在急剧减少,已经濒临灭绝,随之灭绝的不光有侏儒猪,还有这个生命体身上的寄生虫,这种寄生虫对于调节生物体还有我们未知的功能。

图为侏儒猪
除了因为宿主的灭绝导致寄生虫数量急剧减少,人类保护野生动物的行为,也会使寄生虫的数量减少。为了保护加利福尼亚秃鹰,生物学家开始人工养殖加利福尼亚秃鹰,并且为了保护它,开始消灭在加利福尼亚秃鹰身上的寄生虫,但是加利福尼亚秃鹰在大自然生活了这么长的时间,我们还不知道寄生虫是否对加利福尼亚秃鹰有害,如果贸然地消灭它身上的寄生虫,很有可能对这个种群造成不可预估的影响。

图为加利福尼亚秃鹰
如何保护寄生虫
1、正确认识寄生虫
首先不是所有寄生虫对人体都是有益的,我们保护寄生虫的第一步应该是学会如何正确认识它,面对那些让我们人类患上严重疾病的寄生虫我们不应该保护它们,人类认识的寄生虫数量,仅占寄生虫整个种群的10%,我们首先要建立完善的寄生虫谱系,分清哪些对生物体有害,哪些对生物体有利。有害的及时做好防御措施,而不是极端地想将它们灭绝,有益的就要进行一定程度的保护。
图为科学家研究寄生虫
2、保护物种多样性
寄生虫需要寄生在特定的宿主身上,生物种类的急剧减少就是寄生虫种群减少的主要原因,保护寄生虫首先就要保护它宿主的生物安全。随着人类活动和全球气候的变化,生物种群的数量在急剧减少,我们在保护生物种群数量的同时,也要保护它身上寄生虫的安全。同时在保护生物体的时候也要注意方式方法,分清寄生虫到底对这种生物产生怎样的作用,为什么生物可以长期容忍体内的寄生虫存在,贸然消灭只会对生物保护工作起到负面的作用。

人类的一切恐惧都是来自于对未知的恐惧,对寄生虫的恐惧同样也是如此,我们要做的就是用科学的方式破开未知的迷雾,从而让人类能够更清楚地认识这个庞大的寄生虫种群,尝试与大自然和谐共处,才是自然保护的重中之重。